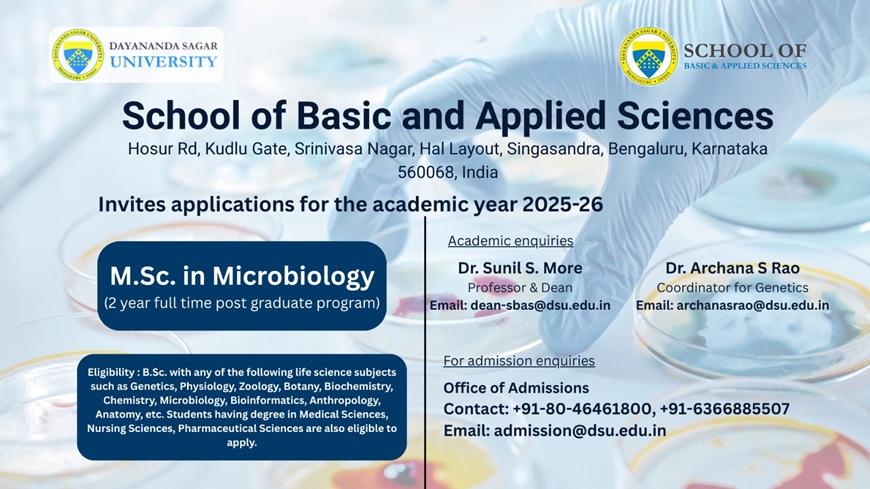
sbas

M.Sc. Microbiology
The School with all its facilities promises an overall development of student community in terms of both intellectual and personality development.
Overview:
The School of Basic and Applied Sciences (SBAS) at Dayananda Sagar University (DSU) offers M.Sc Microbiology. This postgraduate course is for 2 years and this consists of 4 semesters. Microbiology is a large discipline with many different specialties. Microbiology is one of the most popular upcoming streams in the applied sciences. The subject explores the relevance of microbes to the mankind, by enlightening students about their useful and harmful aspects.
Vision
To excel in the field of innovation, teaching and research in the fields of basic and applied sciences encompassing physical, chemical, mathematical and biological sciences and to forge connection between academia and industry.
Mission
To foster creativity and impart research aptitude to produce scholarly individually inclined towards innovation in the field of basic and applied sciences.
The aim of the programme is enable the students compete professionally at local, national and global levels. The knowledge that the students gather will help them in confronting all challenges necessary to find a suitable carrier in science at both academic and industrial levels.
Eligibility M.Sc. Microbiology:
M.Sc. Microbiology is a 2 year full-time postgraduate course with minimum qualification required to apply is a bachelor’s degree. Eligibility for which is B.Sc. in any stream of science with any of the following life science subjects such as Genetics, Zoology, Botany, Biochemistry, Chemistry, Microbiology etc. Students having degree in Medical Sciences, Nursing Sciences, Pharmaceutical Sciences are also eligible to apply from a recognized board.
Program Included:
This course aims to provide knowledge of Microbiology that covers both basic and applied aspects. It encompasses various disciplines such as virology, bacteriology, mycology, phycology, medical microbiology, immunology, microbial biotechnology, fermentation microbiology, food and dairy microbiology, veterinary microbiology, agricultural and environmental microbiology. In simple words, this gives the route map for different areas of microbiology including all living organisms that are so small that they are invisible to the naked eye. These organisms are known to play crucial roles in diagnosis, disease causation, and treatment of pathogens to advanced practical training and major significance to public health. Also, microbes are also useful in making life-saving drugs, nutrient cycling, biodegradation/biodeterioration, manufacturing of biofuels, cleaning up pollution and producing/processing food and drink, agricultural related problems and solution, climate change and food spoilage and its preservation.
Final year students will take up the Project/Dissertation work at DSU, Research Institutes, Pharmaceutical industries, Biotech companies and diagnostic laboratories. Apart from academic schedule DSU is known for its extracurricular activities such as sports, cultural and community activities.
Scope and job opportunities:
Microbiologists have a wide range of career opportunities in the global market. Microbiologists have various scope in industries, government sector, hospitals, university divisions etc. Microbiology graduates are directly considered for the post of Academic researcher, Biomedical scientist, pathologists, health care scientists, epidemiologist, toxicologist, Clinical research associate, Clinical scientist in immunology, Food technologist, Medicinal chemist, Nanotechnologist, Research scientist (life sciences), Technical brewer, Water quality scientist. Career also includes as, Ecologist, Environmental engineer, Forensic scientist, Marine microbiologist, Scientific writer and content developers. Our academic program will also help the aspirants to appear for CSIR-NET, GATE and SET etc.
With the current ongoing pandemic situation, microbiologists are in high demand in various fields like medical researcher, epidemiologist, public health/clinical scientist, research associate, quality control scientist and Biosafety specialist. Many graduates secure high paying jobs in universities, medical institutes, pharmaceutical, food industries, marine field, veterinary field, agricultural and bioscience companies.





